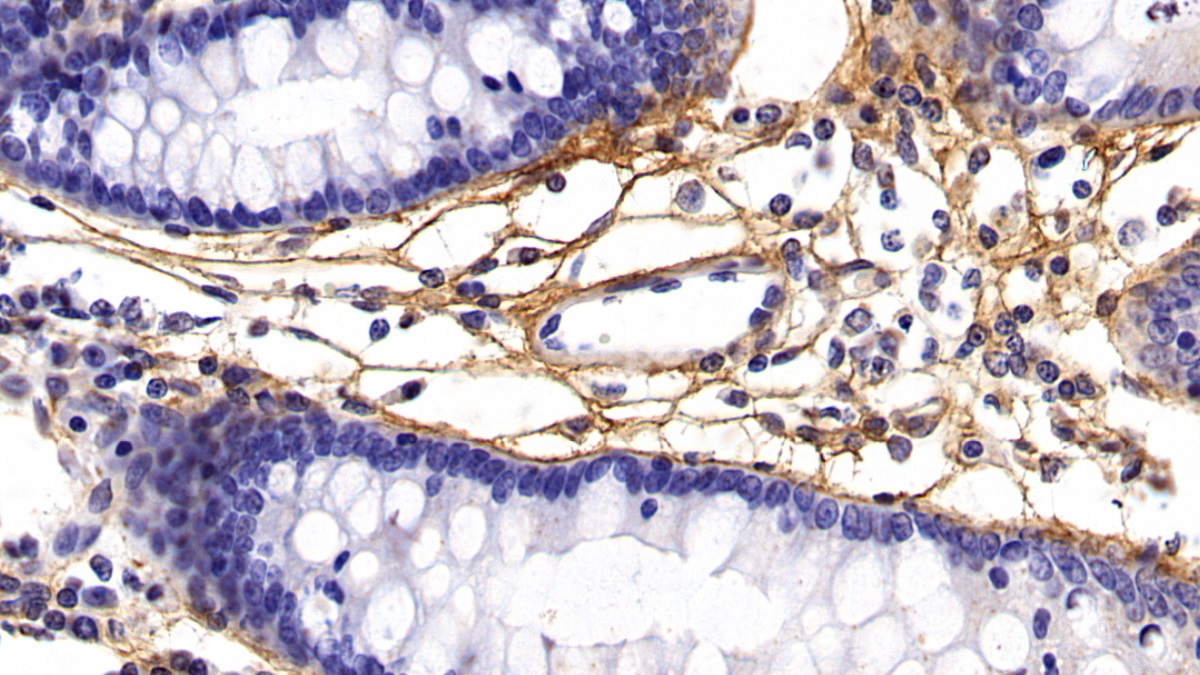

Monoclonal Antibody to Procollagen III N-Terminal Propeptide (PIIINP) 

P3NP; N-Propeptide Of Type III Procollagen; Procollagen III Amino Terminal Propeptide
- UOM
- FOB US$ 171.00 US$ 398.00 US$ 569.00 US$ 1,423.00 US$ 5,690.00
- Quantity
Overview
Properties
- Product No.MAA573Hu26
- Organism SpeciesHomo sapiens (Human) Same name, Different species.
- ApplicationsIHC; FCM
If the antibody is used in flow cytometry, please check FCM antibodies.
Research use only - DownloadInstruction Manual
- CategoryMetabolic pathwayHepatologyBone metabolism
- SourceMonoclonal antibody preparation, Host Mouse
- Ig Isotype IgG2b Kappa, Clone Number C2
- PurificationProtein A + Protein G affinity chromatography
- LabelNone
- Immunogen EPA573Hu61-Eukaryotic Procollagen III N-Terminal Propeptide (PIIINP)
- Buffer Formulation0.01M PBS, pH7.4, containing 0.05% Proclin-300, 50% glycerol.
- TraitsLiquid, Concentration 1mg/mL
Sign into your account
Share a new citation as an author
Upload your experimental result
Review

Contact us
Please fill in the blank.
Specifity
The antibody is a mouse monoclonal antibody raised against PIIINP. It has been selected for its ability to recognize PIIINP in immunohistochemical staining and western blotting.
Usage
Immunohistochemistry: 5-30µg/mL;
Flow cytometry: 10µg/mL;
Optimal working dilutions must be determined by end user.
Storage
Store at 4°C for frequent use. Stored at -20°C in a manual defrost freezer for two year without detectable loss of activity. Avoid repeated freeze-thaw cycles.
Stability
The thermal stability is described by the loss rate. The loss rate was determined by accelerated thermal degradation test, that is, incubate the protein at 37°C for 48h, and no obvious degradation and precipitation were observed. The loss rate is less than 5% within the expiration date under appropriate storage condition.
Giveaways
Increment services
Citations
- Characterization of the specific and sustained GH1 expression induced by rAAV2/1 in normal adult male ratsPubMed: 20204528
- A Biomarker Panel for Non-alcoholic Steatohepatitis (NASH) and NASH-Related FibrosisPubMed: 20532833
- Comparison of Five Liver Fibrosis Indexes with Serum Levels of Laminin and N Terminal Peptide of Procollagen Type III in Chronic Hepatitis PatientsIntechopen: 18785
- Is there benefit in optimising heart failure treatment in over-80 year-old patients? (HF-80 study): study protocol for a randomized controlled trial.Trials: 1745-6215
- Aliskiren and Perindopril Reduce the Levels of Transforming Growth Factor-β in Patients With Non-Diabetic Kidney DiseaseNature: 201214
- Raised circulating tenascin-C in rheumatoid arthritis.PubMed: 23193984
- Serum markers of deranged myocardial collagen turnover: their relation to malignant ventricular arrhythmias in cardioverter-defibrillator recipients with heart failure.PubMed: 23067911
- Diagnostic potential of serum direct markers and non-invasive fibrosis models in patients with chronic hepatitis B.PubMed: 22734888
- Effects of coffee consumption in chronic hepatitis C: a randomized controlled trialPubmed: 23238034
- Procollagen III N-terminal propeptide and desmosine are released by matrix destruction in pulmonary tuberculosisPubmed: 23922364
- Prevalence, etiology and risk factors of pelvic organ prolapse in premenopausal primiparous womenSpringer: Source
- Protective Effects of Norursodeoxycholic Acid Versus Ursodeoxycholic Acid on Thioacetamide-induced Rat Liver FibrosisScienceDirect: S0973688314000073
- Retroperitoneale FibroseSpringer:Source
- The status of the pelvic floor in young primiparous womenWiley:Source
- Clinical significance of markers of collagen metabolism in rheumatic mitral valve diseasePubmed:24603967
- Serum and urinary procollagen III aminoterminal propeptide as a biomarker of obstructive nephropathy in childrenPubmed:24768785
- Fast food diet with CCl4 micro-dose induced hepatic-fibrosis-a novel animal modelPubmed:24884574
- DNMT3A silencing RASSF1A promotes cardiac fibrosis through upregulation of ERK1/2Pubmed:24945829
- Correlation of HBsAg titers with serum fibrotic maker in patients with chronic hepatitis B infection.Pubmed:24974647
- Relation of burden of myocardial fibrosis to malignant ventricular arrhythmias and outcomes in Fabry diseasePubmed:25073565
- B-cell depletion attenuates serological biomarkers of fibrosis and myofibroblast activation in IgG4-related diseasePubmed:25143523
- Biomarkers and Echocardiographic Predictors of Myocardial Dysfunction in Patients with HypertensionPubMed: 25747153
- The Multi-Biomarker Approach for Heart Failure in Patients with HypertensionPubMed: 25984599
- The Relationship of the Degree of Hepatic Fibrosis with Hyaluronic Acid, Type 4 Collagen, and Procollagen Type 3 N-Terminal Peptide Levels in Patients with Chronic Viral HepatitisOpenview: 8A0B8C97D72C61741371F33508760B75
- Pathological characterization and morphometric analysis of hepatic lesions in SHRSP5/Dmcr, an experimental non-alcoholic steatohepatitis model, induced by high-fat and high-cholesterol dietdoi:10.1111
- Prognostic value of collagen turnover biomarkers in cardiac resynchronization therapy: A subanalysis of the TRUST CRT randomized trial populationPubmed:26776557
- Procollagen markers in microdialysate can predict patient outcome after Achilles tendon rupturecontent:2
- Fibrosis of extracellular matrix is related to the duration of the disease but is unrelated to the dynamics of collagen metabolism in dilated cardiomyopathypubmed:27516211
- Left ventricular reverse remodeling is not related to biopsy-detected extracellular matrix fibrosis and serum markers of fibrosis in dilated cardiomyopathy, regardless of the definition used for LVRRpubmed:28004175
- Extracellular microRNA signature in chronic kidney disease.pubmed:28077372
- Renal Denervation Attenuates Multi-Organ Fibrosis and Improves Vascular Remodeling in Rats with Transverse Aortic Constriction Induced Cardiomyopathypubmed:27889753
- Procollagen C-Proteinase Enhancer 1 (PCPE-1) as a Plasma Marker of Muscleand Liver Fibrosis in Mice.pubmed:27458976
- 5-methoxytryptophan is a potential marker for post-myocardial infarction heart failure - apreliminary approach to clinical utility.pubmed:27526355
- Urinary Type III Procollagen Is Associated With Chronic Allograft Dysfunction and Predicts Graft Survival.pubmed:28219585
- Achilles tendon rupture healing is enhanced by intermittent pneumatic compression upregulating collagen type I synthesispubmed:28668970
- Association of HIV infection with biomarkers of kidney injury and fibrosis in the Multicenter AIDS Cohort Studypubmed:28054933
- Profilin‑1 contributes to cardiac injury induced by advanced glycation end‑products in ratspubmed:28901418
- Relationship of biomarkers of extracellular matrix with myocardial function in Type 2 diabetes mellituspubmed:28685602
- Left ventricular reverse remodeling is not related to biopsy‑detected extracellular matrix fibrosis and serum markers of fibrosis in dilated cardiomyopathy, regardless of the definition used for LVRR10.1007/s00380-016-0930-y
- Matrix Degradation in Human Immunodeficiency Virus Type 1–Associated Tuberculosis and Tuberculosis Immune Reconstitution Inflammatory Syndrome: A Prospective Observational Study10.1093/cid/cix231
- 12-month patterns of serum markers of collagen synthesis, transforming growth factor and connective tissue growth factor are similar in new-onset and chronic dilated cardiomyopathy in patients both with and without cardiac fibrosis.pubmed:28460256
- Prognostic value of fibrosis-related markers in dilated cardiomyopathy: A link between osteopontin and cardiovascular events.pubmed:29120858
- Urinary Biomarkers of Kidney Tubular Damage and Risk of Cardiovascular Disease and Mortality in EldersPubmed:29602632
- The Association of Biomarkers of Inflammation and Extracellular Matrix Degradation With the Risk of Abdominal Aortic Aneurysm: The ARIC Studyarticle:10.1007
- Circulating matrix metalloproteinases and procollagen propeptides in inguinal herniaPubmed:29484522
- Assessment of myocardial fibrosis by late gadolinium enhancement imaging and biomarkers of collagen metabolism in chronic rheumatic mitral regurgitation.Pubmed:29443354
- Association between reverse electrical remodeling and cardiac fibrosis markers in patients with cardiac resynchronization therapyPubmed:29512624
- N-терминальный пропептид проколлагена III типа в качестве возможного сывороточного маркера фиброза миокарда у больных сахарным диабетом 2 …:
- Improvement in Hepatic Fibrosis Biomarkers Associated with Chemokine Receptor Inactivation through Mutation or Therapeutic BlockadePubmed: 30239650
- microRNA-29a inhibits cardiac fibrosis in Sprague-Dawley rats by downregulating the expression of DNMT3A.Pubmed: 30297596
- Methods to improve the noninvasive diagnosis and assessment of disease severity in children with suspected nonalcoholic fatty liver disease (NAFLD): Study designDoi: 10.1016/j.cct.2018.10.012
- Association of serum levels of fibrosis-related biomarkers with disease activity in patients with IgG4-related diseasePubmed: 30547825
- Identification and Modulation of Microenvironment is Crucial for Effective MSC Therapy in Acute Lung InjuryPubmed: 30521764
- Direktor: Prof. Dr. med. Andreas Mügge
- Low fibrosis biomarker levels predict cardiac resynchronization therapy responsePubmed: 30988339
- Development and validation of an in vitro 3D model of NASH with severe fibrotic phenotypePubmed: 30972180
- Gum Acacia mitigates diclofenac nephrotoxicity by targeting monocyte chemoattractant protein-1, complement receptor-1 and pro-apoptotic pathwaysPubmed: 31042592
- Validation and Refinement of Noninvasive Methods to Assess Hepatic Fibrosis: Magnetic Resonance Elastography Versus Enhanced Liver Fibrosis IndexPubmed: 31468264
- Type 2 Diabetes Mellitus and Chronic Heart Failure with Midrange and Preserved Ejection Fraction: A Focus on Serum Biomarkers of FibrosisPubmed: 33224989
- Changes in hepatic fibrosis and vitamin D levels after viral hepatitis C eradication using direct-acting antiviral therapyPubmed: 33069226
- A randomized controlled trial of dapagliflozin on left ventricular hypertrophy in people with type two diabetes: the DAPA-LVH trialPubmed: 32578850
- Ассоциации толщины эпикардиального жира и циркулирующих маркеров фиброза миокарда у пациентов с инфарктом миокарда
- Association of Non©\Steroidal Anti©\Inflammatory Drugs with Kidney Health in Ambulatory Older Adults33305369
- Prognostic potential of cardiac structural and functional parameters and N-terminal propeptide of type III procollagen in predicting cardiac fibrosis one year after?¡33431713
- Effect of vitamin D supplementation in patients with chronic hepatitis C after direct-acting antiviral treatment: a randomized, double-blind, placebo-controlled trial33614272
- Soluble CD163 Identifies Those at Risk for Increased Hepatic Inflammation & Fibrosis34104667
- A randomized controlled trial of dapagliflozin on left ventricular hypertrophy in people with type two diabetes32578850
- The Effect of Daily Methylsulfonylmethane (MSM) Consumption on High-Density Lipoprotein Cholesterol in Healthy Overweight and Obese Adults: A Randomized …34684621
- Association between Markers of Fibrosis and Heart Failure Incidence in Patients with Type 2 Diabetes Mellitus34778465
- Dual integrin αvβ3 and αvβ5 blockade attenuates cardiac dysfunction by reducing fibrosis in a rat model of doxorubicin-induced cardiomyopathy34296634
- Simple Predictors for Cardiac Fibrosis in Patients with Type 2 Diabetes Mellitus: The Role of Circulating Biomarkers and Pulse Wave VelocityPubmed:35628969
- Increase in Serum MMP-9 and TIMP-1 Concentrations during Alcohol Intoxication in Adolescents—A Preliminary StudyPubmed:35625637